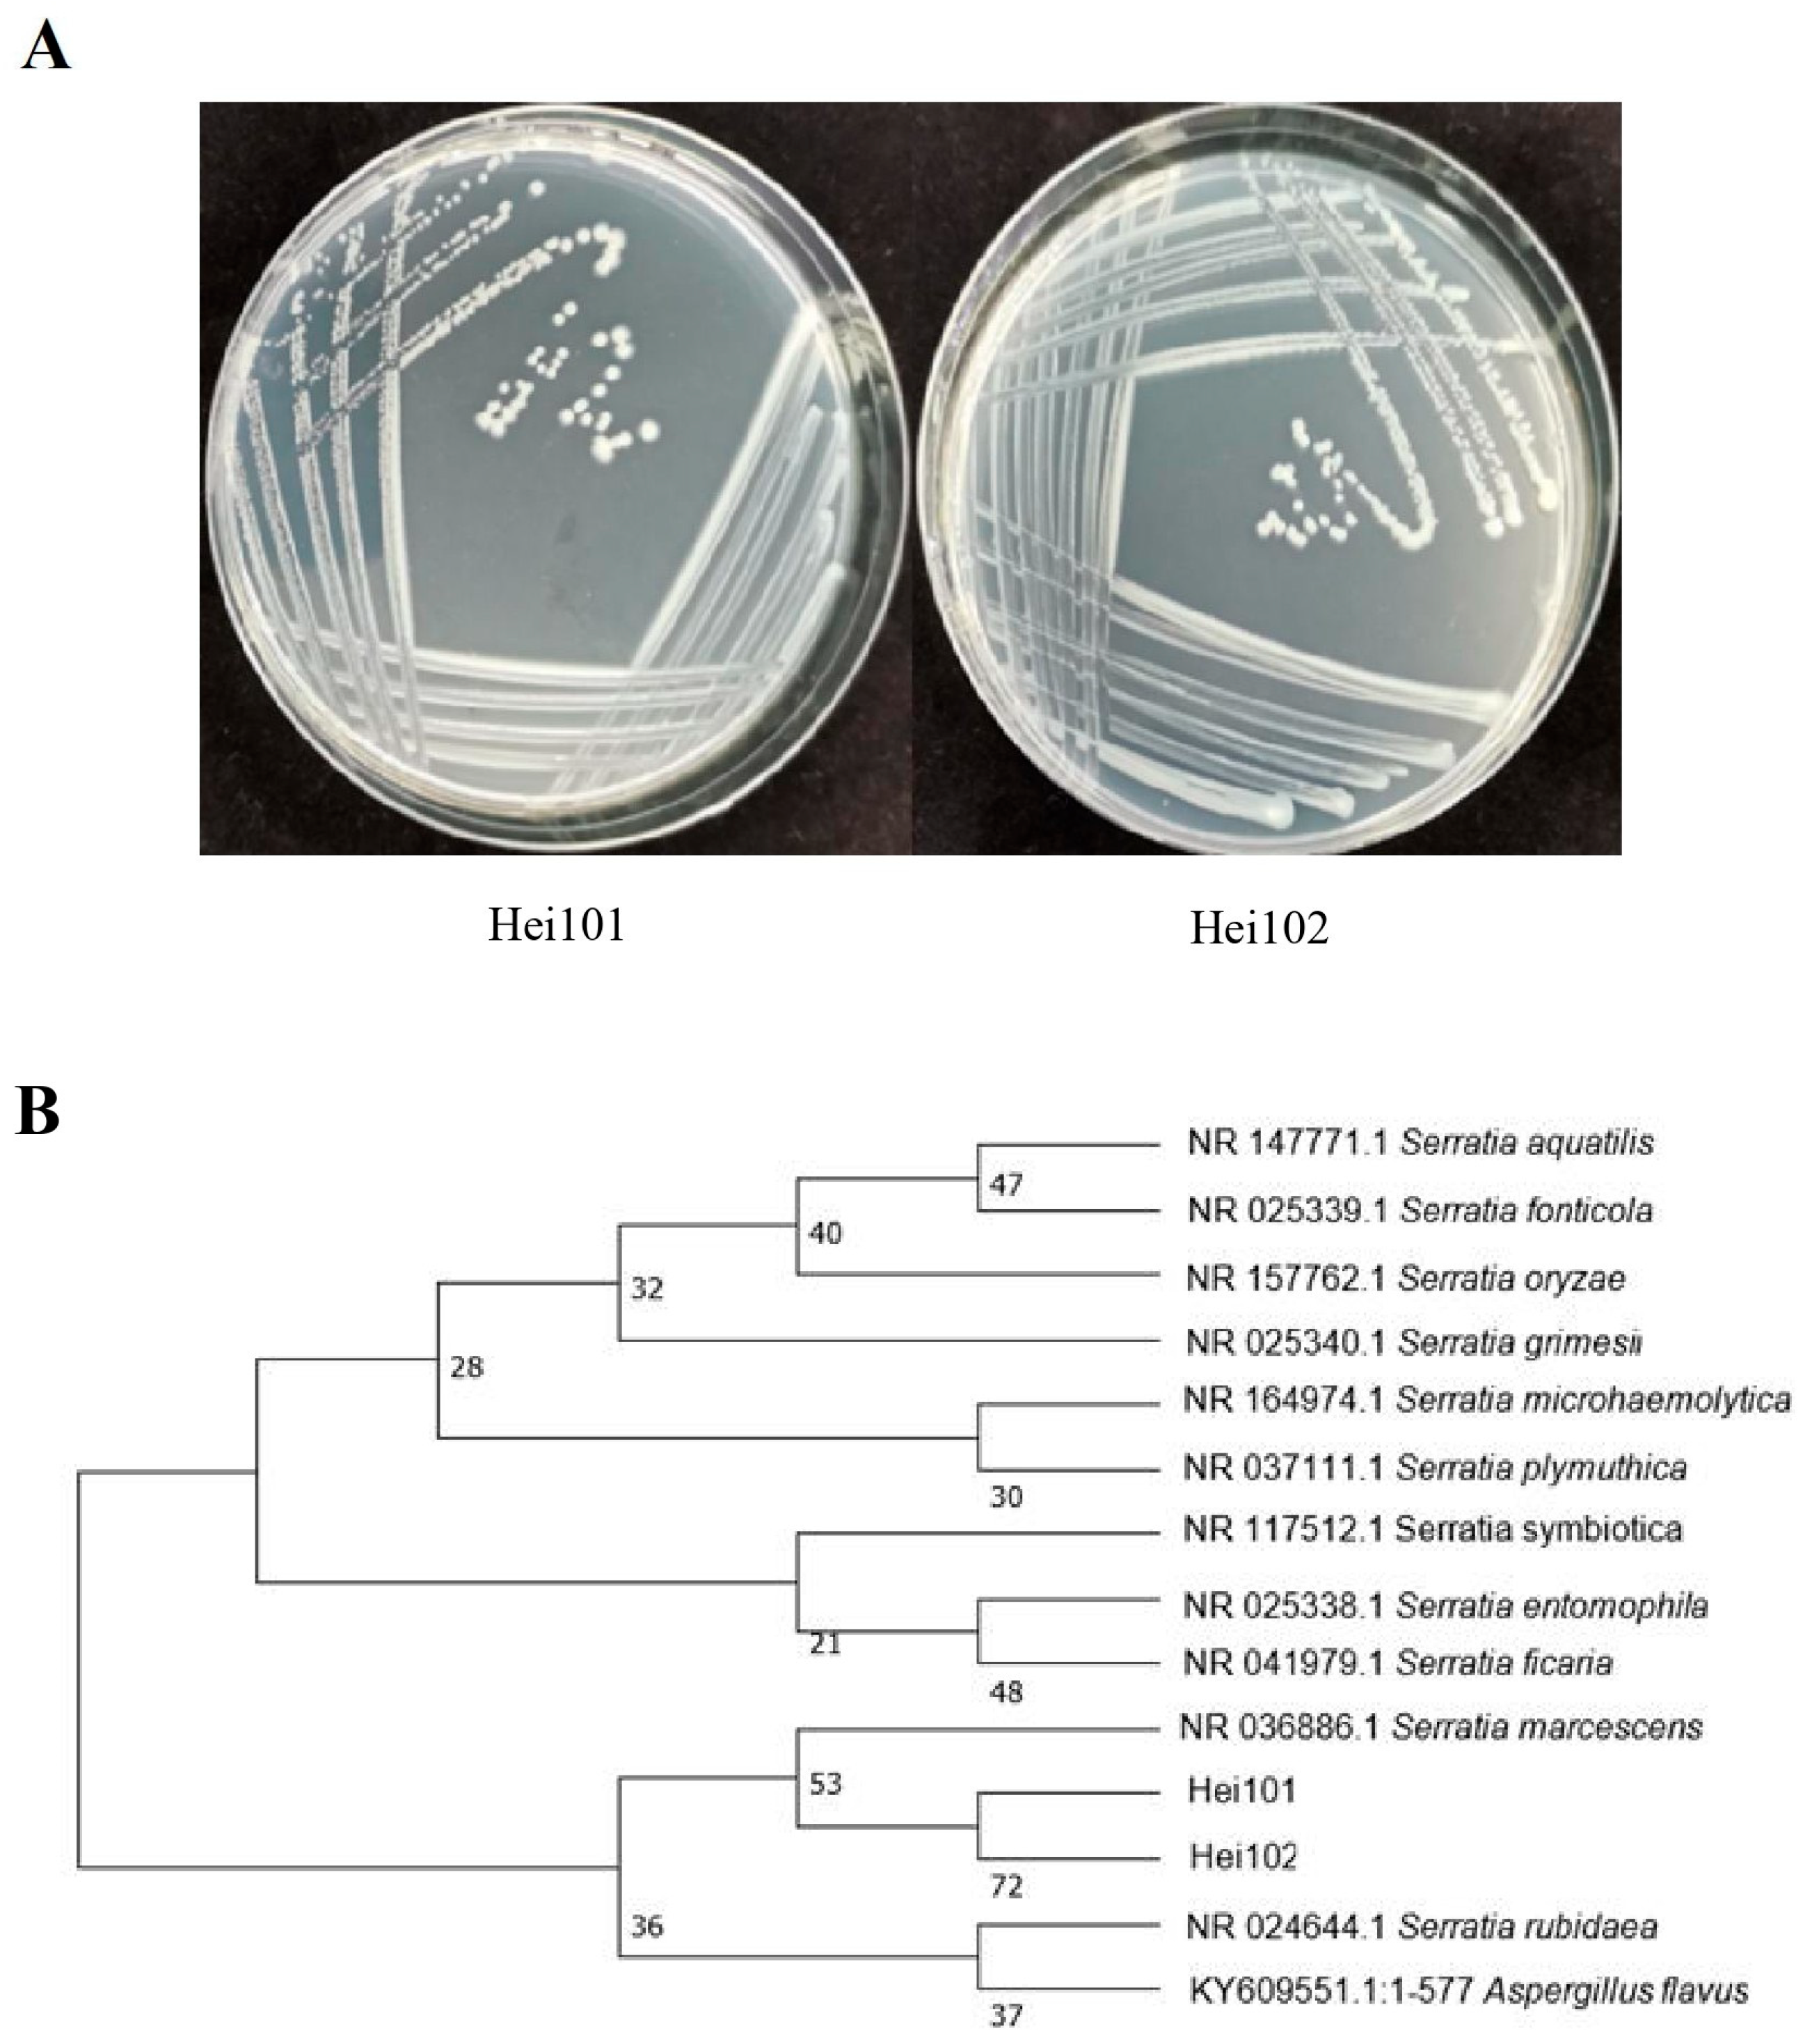
Biology 14 01107 g001 Biology 14 01107 g001

A Bacterium Derived from the Ovary of the Black Soldier Fly (Hermetia illucens) Attract Oviposition of the Host
Simple Summary
Abstract
1. Introduction
2. Materials and Methods
2.1. BSF Colony
2.2. Stress-Induced Oviposition of BSF
2.3. Isolation and Identification of Bacteria
2.4. Whole-Genome Sequencing and Analysis of Serratia marcescens Hei101
2.5. Active Compounds Analysis of Hei101
2.6. Oviposition Selection of BSF
3. Results
3.1. Isolation and Identification of Microorganisms from the Surface of BSF Egg
3.2. Serratia Marcescens Hei101 Attracts the Oviposition of BSF
3.3. Identification of Active Compounds from Serratia marcescens Hei101
3.4. Whole-Genome Sequencing and Analysis of Serratia marcescens Hei101
4. Discussion
5. Conclusions
Supplementary Materials
Author Contributions
Funding
Data Availability Statement
Conflicts of Interest
References
- United Nations Department of Economic and Social Affairs, Population Division. World Population Prospects 2022: Summary of Results; United Nations Publication: New York, NY, USA, 2022; UN DESA/POP/2022/TR/NO. 3. [Google Scholar]
- Cai, M.M.; Li, L.; Zhao, Z.Z.; Zhang, K.; Li, F.; Yu, C.; Yuan, R.F.; Zhou, B.H.; Ren, Z.Q.; Yu, Z.N.; et al. Morphometric characteristic of black soldier fly (Hermetia illucens) greek ano teleia wuhan strain and its egg production improved by selectively inbreeding. Life 2022, 12, 873. [Google Scholar] [CrossRef]
- Cicková, H.; Newton, G.L.; Lacy, R.C.; Kozánek, M. The use of fly larvae for organic waste treatment. Waste Manag. 2015, 35, 68–80. [Google Scholar] [CrossRef] [PubMed]
- Bertinetti, C.; Samayoa, A.C.; Hwang, S.Y. Effects of feeding adults of Hermetia illucens (diptera: Stratiomyidae) on longevity, oviposition, and egg hatchability: Insights into optimizing egg production. J. Insect Sci. 2019, 19, 19. [Google Scholar] [CrossRef]
- De Smet, J.; Wynants, E.; Cos, P.; Van Campenhout, L. Microbial community dynamics during rearing of black soldier fly larvae (Hermetia illucens) and impact on exploitation potential. Appl. Environ. Microbiol. 2018, 84, e02722-17. [Google Scholar] [CrossRef]
- Addeo, N.F.; Li, C.; Rusch, T.W.; Dickerson, A.J.; Tarone, A.M.; Bovera, F.; Tomberlin, J.K. Impact of age, size, and sex on adult black soldier fly [Hermetia illucens L. (Diptera: Stratiomyidae)] thermal preference. J. Insects Food Feed 2022, 8, 129–139. [Google Scholar] [CrossRef]
- Holmes, L.A.; Vanlaerhoven, S.L.; Tomberlin, J.K. Substrate effects on pupation and adult emergence of Hermetia illucens (Diptera: Stratiomyidae). Environ. Entomol. 2013, 42, 370–374. [Google Scholar] [CrossRef]
- Macavei, L.I.; Benassi, G.; Stoian, V.; Maistrello, L. Optimization of Hermetia illucens (L.) Egg laying under different nutrition and light conditions. PLoS ONE 2020, 15, e0232144. [Google Scholar] [CrossRef] [PubMed]
- Zheng, L.Y.; Crippen, T.L.; Holmes, L.; Singh, B.; Pimsler, M.L.; Benbow, M.E.; Tarone, A.M.; Dowd, S.; Yu, Z.N.; Vanlaerhoven, S.L.; et al. Bacteria mediate oviposition by the black soldier fly, Hermetia illucens (L.), (Diptera: Stratiomyidae). Sci. Rep. 2013, 3, 2563. [Google Scholar] [CrossRef]
- Kapsetaki, S.E.; Tzelepis, I.; Avgousti, K.; Livadaras, I.; Garantonakis, N.; Varikou, K.; Apidianakis, Y. The bacterial metabolite 2-aminoacetophenone promotes association of pathogenic bacteria with flies. Nat. Commun. 2014, 5, 4401. [Google Scholar] [CrossRef]
- Stensmyr, M.C.; Dweck, H.K.M.; Farhan, A.; Ibba, I.; Strutz, A.; Mukunda, L.; Linz, J.; Grabe, V.; Steck, K.; Lavista-Llanos, S.; et al. A conserved dedicated olfactory circuit for detecting harmful microbes in drosophila. Cell 2012, 151, 1345–1357. [Google Scholar] [CrossRef]
- Wang, Y.; Li, Y.Y.; Yu, G.H.; Cheng, P.; Yan, X. Research progress on the oviposition mechanism of black soldier fly, Hermetia illucens L. J. Zhongkai Univ. Agric. Eng. 2025, 38, 57–63. [Google Scholar]
- Zhao, J.; Cheng, P.; Wang, Y.; Yan, X.; Xu, Z.; Peng, D.; Yu, G.; Shao, M. Using kin discrimination to construct synthetic microbial communities of bacillus subtilis strains impacts the growth of black soldier fly larvae. Insect Sci. 2024, 31, 1943–1959. [Google Scholar] [CrossRef] [PubMed]
- Lindgreen, S. AdapterRemoval: Easy cleaning of next-generation sequencing reads. BMC Res. 2012, 5, 337. [Google Scholar] [CrossRef]
- Luo, R.; Liu, B.; Xie, Y.; Li, Z.; Huang, W.; Yuan, J.; He, G.; Chen, Y.; Pan, Q.; Liu, Y. SOAPdenovo2: An empirically improved memory-efficient short-read de novo assembler. Gigascience 2012, 1, 2047-217X-1-18. [Google Scholar] [CrossRef] [PubMed]
- Bankevich, A.; Nurk, S.; Antipov, D.; Gurevich, A.A.; Dvorkin, M.; Kulikov, A.S.; Lesin, V.M.; Nikolenko, S.I.; Pham, S.; Prjibelski, A.D.; et al. SPAdes: A new genome assembly algorithm and its applications to single-cell sequencing. J. Comput. Biol. 2012, 19, 455–477. [Google Scholar] [CrossRef]
- Coil, D.; Jospin, G.; Darling, A.E. A5-miseq: An updated pipeline to assemble microbial genomes from illumina MiSeq data. Bioinformatics 2015, 31, 587–589. [Google Scholar] [CrossRef]
- Kolmogorov, M.; Yuan, J.; Lin, Y.; Pevzner, P.A. Assembly of long, error-prone reads using repeat graphs. Nat. Biotechnol. 2019, 37, 540. [Google Scholar] [CrossRef]
- Wick, R.R.; Judd, L.M.; Gorrie, C.L.; Holt, K.E. Unicycler: Resolving bacterial genome assemblies from short and long sequencing reads. PLoS Comput. 2017, 13, e1005595. [Google Scholar] [CrossRef]
- Walker, B.J.; Abeel, T.; Shea, T.; Priest, M.; Abouelliel, A.; Sakthikumar, S.; Cuomo, C.A.; Zeng, Q.D.; Wortman, J.; Young, S.K.; et al. Pilon: An integrated tool for comprehensive microbial variant detection and genome assembly improvement. PLoS ONE 2014, 9, e112963. [Google Scholar] [CrossRef]
- Tatusova, T.; Dicuccio, M.; Badretdin, A.; Chetvernin, V.; Nawrocki, E.P.; Zaslavsky, L.; Lomsadze, A.; Pruitt, K.; Borodovsky, M.; Ostell, J. NCBI prokaryotic genome annotation pipeline. Nucleic. Acids. Res. 2016, 44, 6614–6624. [Google Scholar] [CrossRef]
- Kalvari, I.; Nawrocki, E.P.; Argasinska, J.; Quinones-Olvera, N.; Finn, R.D.; Bateman, A.; Petrov, A.I. Non-coding RNA analysis using the rfam database. Curr. Protoc. Bioinform. 2018, 62, e51. [Google Scholar] [CrossRef]
- Moriya, Y.; Itoh, M.; Okuda, S.; Yoshizawa, A.C.; Kanehisa, M. KAAS: An automatic genome annotation and pathway reconstruction server. Nucleic. Acids. Res. 2007, 35 (Suppl. 2), W182–W185. [Google Scholar] [CrossRef]
- Powell, S.; Forslund, K.; Szklarczyk, D.; Trachana, K.; Roth, A.; Huerta-Cepas, J.; Gabaldón, T.; Rattei, T.; Creevey, C.; Kuhn, M.; et al. EggNOG v4.0: Nested orthology inference across 3686 organisms. Nucleic. Acids. Res. 2014, 42, D231–D239. [Google Scholar] [CrossRef] [PubMed]
- Stothard, P.; Wishart, D.S. Circular genome visualization and exploration using CGView. Bioinformatics 2005, 21, 537–539. [Google Scholar] [CrossRef] [PubMed]
- Klüber, P.; Arous, E.; Jerschow, J.; Fraatz, M.; Bakonyi, D.; Rühl, M.; Zorn, H. Fatty acids derived from oviposition systems guide female black soldier flies (Hermetia illucens) toward egg deposition sites. Insect Sci. 2024, 31, 1231–1248. [Google Scholar] [CrossRef] [PubMed]
- Yang, S.; Li, Y.; Mai, Y.; Ruan, R.T.; Song, A.D.; Wang, F.Q.; Chen, H.G. Isolation and identification of egg-associated bacteria of Hermetia illucens (Diptera: Stratiomyidae) and their effects on its adult oviposition behavior. Acta Entomol. Sin. 2017, 60, 163–172. [Google Scholar]
- Gorrens, E.; Van Moll, L.; Frooninckx, L.; De Smet, J.; Van Campenhout, L. Isolation and identification of dominant bacteria from black soldier fly larvae (Hermetia illucens) envisaging practical applications. Front. Microbiol. 2021, 12, 665546. [Google Scholar] [CrossRef]
- Lee, K.S.; Yun, E.Y.; Goo, T.W. Evaluation of the antimicrobial activity of an extract of Lactobacillus casei-infected Hermetia illucens larvae produced using an automatic injection system. Animals 2020, 10, 2121. [Google Scholar] [CrossRef]
- Peng, T.H.; Wei, L.K.; Chiang, E.; Yoon, M. Antibacterial properties of chitosan isolated from the black soldier fly, Hermetia illucens. Sains Malays. 2022, 51, 3923–3935. [Google Scholar] [CrossRef]
- Weisskopf, L.; Schulz, S.; Garbeva, P. Microbial volatile organic compounds in intra-kingdom and inter-kingdom interactions. Nat. Rev. Microbiol. 2021, 19, 391–404. [Google Scholar] [CrossRef]
- Leroy, P.D.; Sabri, A.; Heuskin, S.; Thonart, P.; Lognay, G.; Verheggen, F.J.; Francis, F.; Brostaux, Y.; Felton, G.W.; Haubruge, E. Microorganisms from aphid honeydew attract and enhance the efficacy of natural enemies. Nat. Commun. 2011, 2, 348. [Google Scholar] [CrossRef] [PubMed]
- Li, H.J.; Ren, L.; Xie, M.X.; Gao, Y.; He, M.Y.; Hassan, B.; Lu, Y.Y.; Cheng, D.F. Egg-surface bacteria are indirectly associated with oviposition aversion in Bactrocera dorsalis. Curr. Biol. 2020, 30, 4432. [Google Scholar] [CrossRef] [PubMed]
- Sato, A.; Tanaka, K.M.; Yew, J.Y.; Takahashi, A. Drosophila suzukii avoidance of microbes in oviposition choice. R. Soc. Open Sci. 2021, 8, 201601. [Google Scholar] [CrossRef] [PubMed]
- Suh, E.; Choe, D.H.; Saveer, A.M.; Zwiebel, L.J. Suboptimal larval habitats modulate oviposition of the malaria vector mosquito Anopheles coluzzii. PLoS ONE 2016, 11, e0149800. [Google Scholar] [CrossRef]
- Mahadevan, V.P.; Galagovsky, D.; Knaden, M.; Hansson, B.S. Preference for and resistance to a toxic sulfur volatile opens up a unique niche in Drosophila busckii. Nat. Commun. 2025, 16, 767. [Google Scholar] [CrossRef]
- Schoelitsz, B.; Mwingira, V.; Mboera, L.; Beijleveld, H.; Koenraadt, C.; Spitzen, J.; van Loon, J.; Takken, W. Chemical mediation of oviposition by Anopheles mosquitoes: A push-pull system driven by volatiles associated with larval stages. J. Chem. Ecol. 2020, 46, 397–409. [Google Scholar] [CrossRef]
- Michishita, R.; Shimoda, M.; Furukawa, S.; Uehara, T. Inoculation with black soldier fly larvae alters the microbiome and volatile organic compound profile of decomposing food waste. Sci. Rep. 2023, 13, 4297. [Google Scholar] [CrossRef]

| Strain | No. of Egg Clusters | p Value | |
|---|---|---|---|
| Treatment | Control | ||
| Cellulosimicrobium sp. Heo2h808 | 0.5 ± 0.22 | 1.17 ± 0.4 | 0.286 |
| Glutamicibacter sp. Heo1h2404 | 4.83 ± 1.22 | 2.17 ± 0.65 | 0.203 |
| Stahphylococcus xylosus Heo2h2404 | 0.83 ± 0.54 | 2.67 ± 0.99 | 0.247 |
| Serratia marcescens Hei101 | 5.88 ± 1.25 | 1.75 ± 0.45 | 0.004 |
| Rhizobium sp. Heo2h816 | 0.25 ± 0.16 | 0.25 ± 0.16 | 1.000 |
| Bacillus amyloliquefaciens Heo1h801 | 1.13 ± 0.67 | 1.13 ± 0.51 | 1.000 |
| Microbacterium aurum Heo2h817 | 1.67 ± 0.42 | 0.17 ± 0.17 | 0.541 |
| Peak | Retention Time /min | Matching Degree /% | Chemical Formula | Peak Area | Area Percentage /% | CAS | Compound |
|---|---|---|---|---|---|---|---|
| 1 | 4.438 | 84.0 | C4H10N2 | 298345000 | 96.58 | 4025-37-0 | 2-(Aziridin-1-yl)ethan-1-amine |
| 2 | 7.912 | 87.3 | C3H6O | 425148 | 1.37 | 67-64-1 | acetone |
| 3 | 15.898 | 88.0 | C2H6S2 | 6331841 | 2.05 | 624-92-0 | dimethyl disulfide |
Disclaimer/Publisher’s Note: The statements, opinions and data contained in all publications are solely those of the individual author(s) and contributor(s) and not of MDPI and/or the editor(s). MDPI and/or the editor(s) disclaim responsibility for any injury to people or property resulting from any ideas, methods, instructions or products referred to in the content. |
© 2025 by the authors. Licensee MDPI, Basel, Switzerland. This article is an open access article distributed under the terms and conditions of the Creative Commons Attribution (CC BY) license (https://creativecommons.org/licenses/by/4.0/).
Share and Cite
He, M.; Wang, Y.; Xu, W.; Yu, G.; Yan, X. A Bacterium Derived from the Ovary of the Black Soldier Fly (Hermetia illucens) Attract Oviposition of the Host. Biology 2025, 14, 1107. https://doi.org/10.3390/biology14091107
He M, Wang Y, Xu W, Yu G, Yan X. A Bacterium Derived from the Ovary of the Black Soldier Fly (Hermetia illucens) Attract Oviposition of the Host. Biology. 2025; 14(9):1107. https://doi.org/10.3390/biology14091107
Chicago/Turabian StyleHe, Muyang, Yi Wang, Wenxuan Xu, Guohui Yu, and Xun Yan. 2025. "A Bacterium Derived from the Ovary of the Black Soldier Fly (Hermetia illucens) Attract Oviposition of the Host" Biology 14, no. 9: 1107. https://doi.org/10.3390/biology14091107
APA StyleHe, M., Wang, Y., Xu, W., Yu, G., & Yan, X. (2025). A Bacterium Derived from the Ovary of the Black Soldier Fly (Hermetia illucens) Attract Oviposition of the Host. Biology, 14(9), 1107. https://doi.org/10.3390/biology14091107

